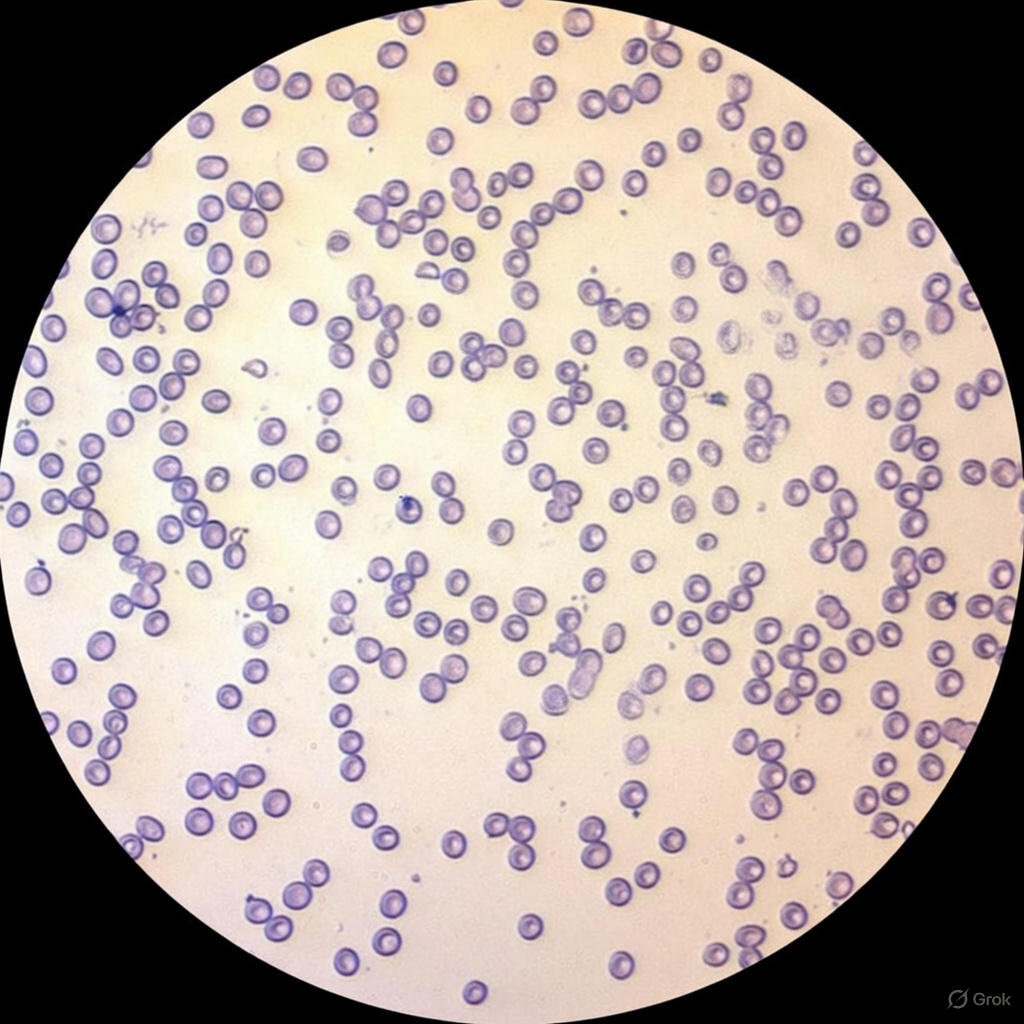
Aplastic Anemia Bone Marrow Smear, Microscope Slide - Dr Wong Anatomy

No Products in the Cart
Aplastic Anemia Bone Marrow Smear, Prepared Microscope Slide
Dr Wong Anatomy® Prepared Slides show superior specimens across disciplines like Zoology, Botany, General Biology, Histology, Parasitology, Embryology, Fungi, Monera, and Protista. Purchase individually or in convenient sets.
Anatomy Models Warranty Period: 3 Years
Medical simulators Warranty Period: 5 Years (Injection pads and suture pads are not included)
Your satisfaction is our top priority. If there is an issue with the product during the warranty period, we will usually replace it with a new one instead of repairing it.
Inicie sesión y agregará el producto a su lista de deseos

